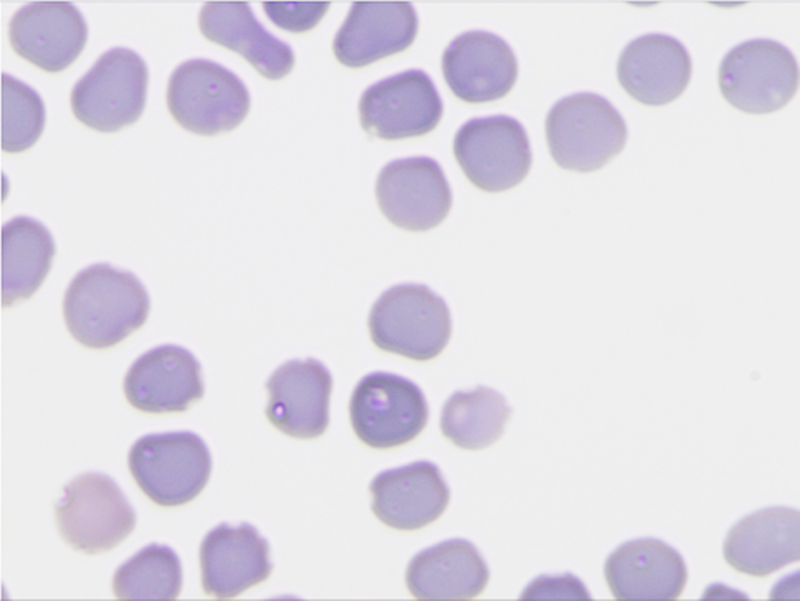
600그림4.png

VIP동물의료센터는
심도 있는 치료까지 책임집니다.
빈혈과 고열로 내원한 강아지, 바베시아증 치료 성공 사례
- 작성자
- 관리자
- 등록일
- 2026-01-14
- 조회수
- 475
■ 환자 기본 정보
동물 이름 : 레이(가명)
나이 : 5살령
성별 : 중성화 암컷
품종 : 장모치와와
주요 증상 : 빈혈

■ 내원 당시 환자의 상태
5살령의 중성화된 암컷 강아지가 기력 저하와 식욕 저하를 주소로 내원하였습니다.
보호자에 따르면, 내원 약 2주 전부터 전반적인 컨디션 저하가 점차 관찰되었으며, 내원 2일 전부터는 식욕이 완전히 소실된 상태였습니다.
신체검사 결과, 체온은 39.8도로 발열이 확인되었고, 점막은 창백하였으며 심잡음이 청진되었습니다.
■ 검사 방법 및 결과
발열, 기력 저하 및 식욕 절폐의 원인을 확인하기 위해 전반적인 검사를 진행하였습니다. 검사 항목으로는 혈액검사, 영상검사(방사선 검사 및 초음파 검사), 그리고 PCR 검사가 포함되었습니다.
혈액검사 결과, 빈혈을 나타내는 HCT 수치는 9.5%로 확인되어 중증의 빈혈 상태로 판단되었습니다. 또한 이를 보상하기 위한 재생성 반응이 증가되어 재생성 빈혈로 진단하였습니다.
혈소판 수치 역시 정상 범위보다 감소되어 있었으며, 전신 염증 지표인 CRP는 200 이상으로 측정 한계를 초과할 정도로 높게 확인되었습니다.
아울러 간 수치(ALP, GGT)의 경미한 상승이 관찰되었고, 황달 지표인 Total bilirubin 역시 1.1로 정상 범위를 초과하여 상승된 상태였습니다. ▼


추가적인 평가를 위해 말초혈액도말 검사를 시행하였습니다.
본 검사는 적혈구 내 원충 감염 여부를 확인하고, spherocyte 형성이나 적혈구 응집 소견이 있는지를 평가하기 위해 진행되었습니다.
검사 결과, 말초혈액도말상 적혈구 내에서 바베시아 형태의 원충이 관찰되었습니다.
말초혈액도말 검사만으로 바베시아증을 확진하기에는 제한이 있을 수 있으나, 임상 증상 및 다른 검사 결과와 종합할 경우 진단에 중요한 단서를 제공하는 검사 소견으로 판단되었습니다.
동시에 빈혈의 원인을 감별하고 확진하기 위해 빈혈 PCR 검사를 의뢰하였습니다.
그 결과, Babesia gibsoni 감염이 확인되어 본 환자는 바베시아증으로 최종 진단되었습니다.▼

■ 치료 및 경과
1. 수혈 치료 (Blood Transfusion)
HCT 수치가 9.5%로 생명을 위협할 수 있는 중증 빈혈 상태로 판단되어 즉시 수혈 치료를 시작하였습니다.
전혈 160 mL를 수혈하였으며, 수혈 중 및 수혈 후 부작용 발생 여부에 대해 면밀한 경과 관찰을 진행하였습니다.
2. 보조적 치료 (Supportive Care)
전신 상태 안정을 위해 탈수 교정 및 순환 혈량 유지를 목적으로 수액 요법을 시행하였습니다.
고열 조절을 위해 해열제를 투여하였으며, 용혈성 스트레스로 인한 간 손상을 예방하기 위해 간 보호제를 병행 투여하였습니다.
또한 위장관 보호를 위한 약물과 항산화제 처치를 함께 진행하였습니다.
3. 항원충 치료 (AA Protocol)
Babesia gibsoni 감염에 대한 치료로, 현재 골드 스탠다드로 알려진 AA protocol을 적용하였습니다.
Atovaquone(아토바쿠온)과 Azithromycin(아지스로마이신)을 병용하여 총 10일간 경구 투여하였습니다.
치료 시작 이후 빈혈 수치는 점진적으로 호전되는 양상을 보였으며, 약물 복용 종료 시 HCT는 41.6%로 정상 범위 내까지 회복된 것이 확인되었습니다. ▼

치료 종료 후 4주 시점에서 추적 PCR 검사를 다시 진행하였습니다.
그 결과, Babesia 항목 모두에서 음성이 확인되어 치료가 성공적으로 종료되었습니다. ▼

■ 강아지 바베시아증
강아지 바베시아증은 Babesia 속에 속하는 원충(protozoa) 에 의해 발생하는 혈액기생충성 질환입니다.
주로 진드기를 통해 감염되며, 체내로 침입한 원충은 반려견의 적혈구 안에서 증식하면서 적혈구를 파괴하여 용혈성 빈혈을 유발합니다.
강아지에서 주로 문제되는 바베시아의 종류는 다음과 같습니다.
Babesia canis: 비교적 크기가 큰 원충으로, 유럽과 아프리카 지역에서 흔하게 보고됩니다.
Babesia gibsoni: 크기가 작은 원충으로, 한국을 포함한 아시아 지역에서 주로 확인되며, 치료에 대한 저항성이 높고 만성화되는 경향이 있는 것이 특징입니다.
이 두 종은 감염 경로는 유사하지만, 치료 반응과 예후에서 차이를 보일 수 있어 정확한 진단과 종 감별이 중요합니다.
감염 경로는 대부분 감염된 진드기가 반려견의 피부를 물면서 원충이 혈류로 침투하는 방식으로 이루어집니다.

강아지 바베시아증은 치료도 중요하지만, 무엇보다 예방이 가장 중요한 질환입니다.
매달 꾸준한 외부기생충 예방제 사용은 필수이며, 풀밭이나 산책로를 다녀온 후에는 반려견의 피부와 귀, 겨드랑이, 사타구니 등을 중심으로 진드기 부착 여부를 꼼꼼히 확인하고 즉시 제거해야 합니다.
만약 진드기 물림이 의심되거나 확인된 경우에는 증상이 없더라도 조기에 동물병원을 방문하여 검사를 받는 것이 중요합니다.
또한 바베시아증 치료가 종료된 이후에도 재발 여부를 확인하기 위해 일정 기간 동안 정기적인 PCR 검사와 혈액검사를 통한 추적 관리가 필요합니다.
VIP동물의료센터 노원점 임나연 과장